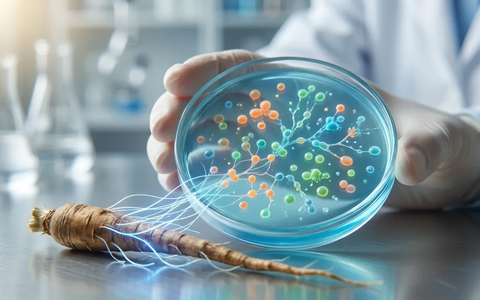
Wegwarte-Inulin hilft Darm nach Antibiotika-Therapie - Foto: über boerse-global.de

Thema: Ballaststoff
Hafer-Beta-Glucan, Cholesterin-Killer

Hafer-Beta-Glucan: Der natürliche Cholesterin-Killer - Foto: über boerse-global.de

Hafer-Beta-Glucan: Der natürliche Cholesterin-Killer
boerse-global.de, 03.02.26 17:32 Uhr
Haferkleie, Cholesterinspiegel
Der lösliche Ballaststoff Beta-Glucan in Haferkleie reduziert ...
Haferkleie senkt nachweislich den Cholesterinspiegel
boerse-global.de, 01.02.26 08:40 Uhr
Resistente, Stärke
Studien belegen dass der Ballaststoff aus abgekühlten Kartoffeln ...
Resistente Stärke: Der unterschätzte Abnehm-Helfer im Darm
boerse-global.de, 30.01.26 00:13 Uhr
Haferkur, Renaissance
Studien belegen die Wirksamkeit der traditionellen Haferkur. ...
Haferkur erlebt Renaissance: Senkt Cholesterin und stärkt den Darm
boerse-global.de, 23.01.26 21:52 Uhr
Wegwarte-Inulin, Darm
Der präbiotische Ballaststoff Inulin fördert gezielt nützliche ...
Wegwarte-Inulin hilft Darm nach Antibiotika-Therapie
boerse-global.de, 23.01.26 16:05 Uhr
Akazienfaser, Ballaststoff
Akazienfaser erobert als sanfter Ballaststoff den Markt
boerse-global.de, 22.01.26 10:00 Uhr
Zichorienwurzel, Inulin
Studien belegen dass der präbiotische Ballaststoff Inulin ...
Zichorienwurzel: Inulin hilft beim Abnehmen
boerse-global.de, 20.01.26 08:24 Uhr
Pektin, Appetitbremse-Effekt
Der Ballaststoff Pektin aus Äpfeln und Zitrusfrüchten ...
Pektin: Der natürliche Appetitbremse-Effekt fürs Festessen
boerse-global.de, 24.12.25 23:41 Uhr
Inulin, Leber-Schutz
Eine aktuelle Studie belegt dass der Ballaststoff Inulin ...